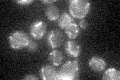
YJL071W
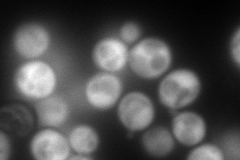
YJL071W
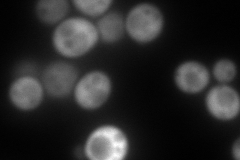
YJL071W
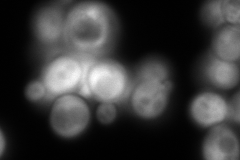
YJL071W
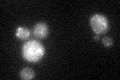
YJL071W
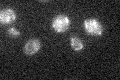
YJL071W

View description
Acetylglutamate synthase (glutamate N-acetyltransferase), mitochondrial enzyme that catalyzes the first step in the biosynthesis of the arginine precursor ornithine; forms a complex with Arg5,6p
Localization:
Intensity:
Fold change:
Significance:
-
C’ GFP library in SD
mitochondria22.26 -
N' NOP1pr-GFP in SD
cytosol293.77 -
N' TEF2pr-mCherry in SD
cytosol254.945 -
N' NATIVEpr-GFP in SD
cytosol767.446 -
N' TEF2pr-VC and Cyto-VN in SD

#N/A0 -
C’ GFP library in SD+DTT
mitochondria20.350.91No -
C’ GFP library in SD+H2O2

mitochondria24.011.07No -
C’ GFP library in Starvation Media
mitochondria18.020.8Yes -
C’ GFP library on the background of Pup2-DaMP

mitochondria -
C’ GFP library on the background of CCT mutant

mitochondria24.63951.10655No
